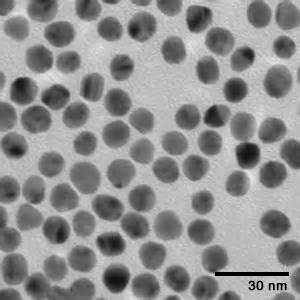

產(chǎn)品分類
Home >
Products > Gold Nanoparticles> PEGylated Gold Nanoparticle> Gold Nanoparticles,Au-mPEG550(10nm)
Gold Nanoparticles,Au-mPEG550(10nm)
Catalog # | Pkg Size | Price | Quantity | Shopping Cart |
---|---|---|---|---|
R-GP010005 | 25ml | ¥ 2800 | 加入購物車 | |
R-GP010005 | 50ml | ¥ 4200 | 加入購物車 | |
R-GP010005 | 100ml | ¥ 6500 | 加入購物車 |
結(jié)構(gòu)式
外觀 | 酒紅色液體 |
分子量 | N/A |
溶解度 | 不溶于水 |
CAS號(hào) | 7440-57-5 |
質(zhì)量控制 | ±2nm |
儲(chǔ)存條件 | 2-8℃ |
保存時(shí)間 | 6個(gè)月 |
其他信息 | N/A |
納米金粒子經(jīng)腫瘤靶向分子修飾用于腫瘤熱療已經(jīng)得到證實(shí),常用的是經(jīng)PEG修飾或是連接上特異識(shí)別癌細(xì)胞表面的抗體。PEG可增加納米金粒子的生物相容性和生物穩(wěn)定性。由于在合成納米金的過程中大量使用表面活性劑CTAB使得納米金在血液中極不穩(wěn)定,然而經(jīng)PEG修飾后的納米金毒性大大地降低了,具體了良好的生物相容性聚集作用也有所改善。
親,說點(diǎn)什么吧,您的評(píng)價(jià)對(duì)其它買家很有幫助哦~
“好評(píng),中評(píng),差評(píng)”請(qǐng)?zhí)顚懫湟慌秪
您的昵稱
相關(guān)產(chǎn)品
Gold Nanoparticles,Au-mPEG550(20nm) | PEG化Au納米粒子可以增加納米顆粒的生物相容性,增加其在體內(nèi)循環(huán)時(shí)間,表面功能化官能團(tuán)可以有效結(jié)合DNA,抗體,多肽,蛋白質(zhì),小分子等實(shí)現(xiàn)對(duì)不同靶標(biāo)物質(zhì)的特異性檢測(cè)。 |
Gold Nanoparticles,Au-mPEG1000(5nm) | PEG化Au納米粒子可以增加納米顆粒的生物相容性,增加其在體內(nèi)循環(huán)時(shí)間,表面功能化官能團(tuán)可以有效結(jié)合DNA,抗體,多肽,蛋白質(zhì),小分子等實(shí)現(xiàn)對(duì)不同靶標(biāo)物質(zhì)的特異性檢測(cè)。 |
Gold Nanoparticles,Au-mPEG1000(20nm) | PEG化Au納米粒子可以增加納米顆粒的生物相容性,增加其在體內(nèi)循環(huán)時(shí)間,表面功能化官能團(tuán)可以有效結(jié)合DNA,抗體,多肽,蛋白質(zhì),小分子等實(shí)現(xiàn)對(duì)不同靶標(biāo)物質(zhì)的特異性檢測(cè)。 |
Gold Nanoparticles,Au-mPEG1000(50nm) | PEG化Au納米粒子可以增加納米顆粒的生物相容性,增加其在體內(nèi)循環(huán)時(shí)間,表面功能化官能團(tuán)可以有效結(jié)合DNA,抗體,多肽,蛋白質(zhì),小分子等實(shí)現(xiàn)對(duì)不同靶標(biāo)物質(zhì)的特異性檢測(cè)。 |
Gold Nanoparticles,Au-mPEG1000(80nm) | PEG化Au納米粒子可以增加納米顆粒的生物相容性,增加其在體內(nèi)循環(huán)時(shí)間,表面功能化官能團(tuán)可以有效結(jié)合DNA,抗體,多肽,蛋白質(zhì),小分子等實(shí)現(xiàn)對(duì)不同靶標(biāo)物質(zhì)的特異性檢測(cè)。 |
Gold Nanoparticles,Au-mPEG2000(10nm) | PEG化Au納米粒子可以增加納米顆粒的生物相容性,增加其在體內(nèi)循環(huán)時(shí)間,表面功能化官能團(tuán)可以有效結(jié)合DNA,抗體,多肽,蛋白質(zhì),小分子等實(shí)現(xiàn)對(duì)不同靶標(biāo)物質(zhì)的特異性檢測(cè)。 |